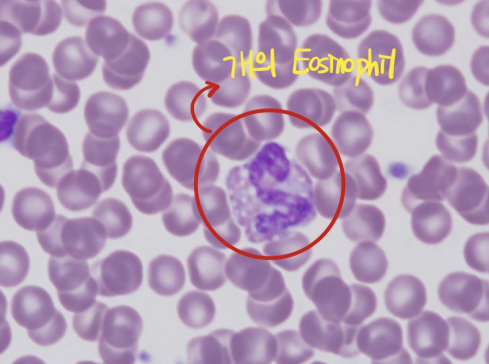
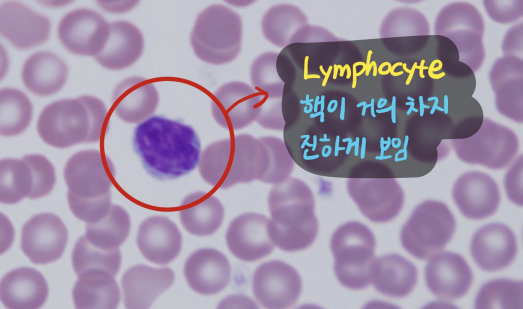

적혈구 (RBC, erythrocyte)
- 핵이 없는 오목한 원반 모양 (biconcave disk)
- 개의 적혈구 : central pallor가 뚜렷하게 나타남.
- Hemoglobin이 주변부에 분포하여 중앙에 pale하게 보이는 부분
백혈구 (WBC, leukocyte)
Granulocytes
| Neutrophil (호중구) | |
|---|---|
![]() ![]() | - 적혈구의 2배 크기 (12-15 μm) - 핵이 3~5개로 분엽 - heterochromatin → 진하게 염색됨 |
| Eosinophil (호산구) | |
|---|---|
![]() | - 핵이 2개로 분엽됨 - 10-15 μm - 개에서는 과립이 적고, 공포(vacuolated) 과립도 보임. |
| Basophil (호염구) | |
|---|---|
![]() | - 핵이 2개로 분엽됨 - 10-15 μm - 짙은 보라색 - 개에서는 핵이 리본 묶은 모양, 과립이 안 보임. |
Agranulocytes
| Lymphocyte (림프구) | |
|---|---|
![]() ![]() | - 검푸른 핵이 거의 차지하고 있음 - azurophilic granule이 보이기도 함 |
| Monocyte (단핵구) | |
|---|---|
![]() | - 12-18 μm의 큰 사이즈 - 다형적 핵, 옅게 염색됨 (euchromatin) - 공포(vacuole) 존재 - 세포 표면에 microvilli |
Plasma cell
| Plasma cell (혈장세포) | |
|---|---|
![]() | - 림프구를 닮았으나, 림프구보다 큼. - 차 바퀴 모양의 핵 (heterochromatin이 핵 주변부에 덩어리처럼 모여 있음), 한 쪽으로 쏠려 있음. - 세포질은 RER이 높아 basophilic - Russel body 관찰 : 항체 축적된 것, inclusion body처럼 보임. - Golgi complex : 핵 근처에서 염색되지 않은 채로 관찰됨. |